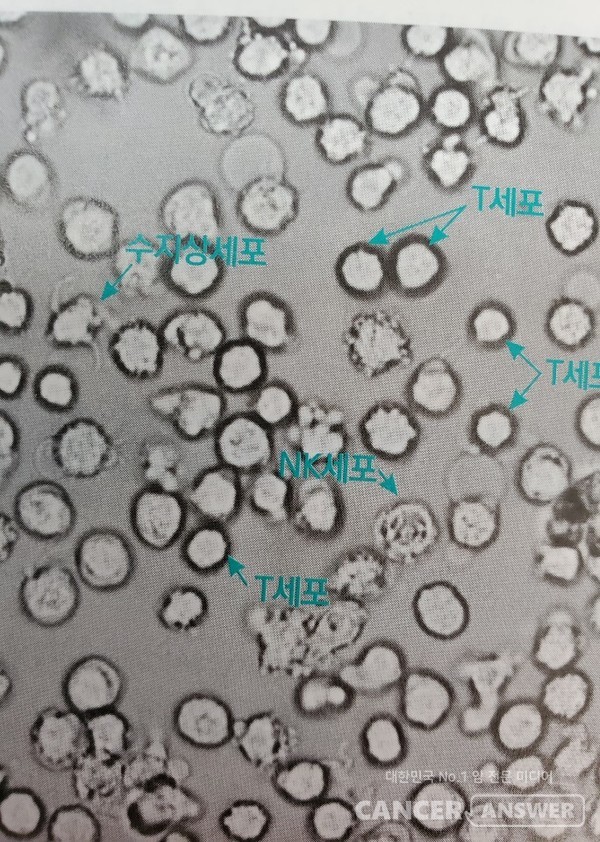
현미경으로 들여다본 백혈구 속의 NK세포, T세포./사진제공=조성훈 교수

NK(자연살해)세포 면역치료라는 암 치료법이 있다. 대학병원 등에서 일반적으로 하는 암 표준치료법(수술, 항암치료, 방사선 치료)은 아니고, 우리 몸의 면역세포 중에서 암과 싸우는 기동타격대 같은 역할을 하는 NK세포의 힘을 키워 암을 치료하는 방법이다.
NK세포는 백혈구와 림프기관, 폐, 간, 장에 존재하는데, 외부에서 침투한 바이러스에 감염된 세포나 암세포를 발견하면 즉시 공격하여 죽인다. 퍼포린(perforin)이라는 단백질을 분비해 감염세포나 암세포의 세포막에 구멍을 내고, 여기에 세포독성물질인 그랜자임(granzyme)을 주입해 세포 자살을 유도한다. NK세포는 또 사이토카인(cytokine)이나 인터페론 감마를 분비해 T세포 등 다른 면역세포를 활성화시키기도 한다. 암 줄기세포를 효과적으로 제거해 재발, 증식, 전이를 막는 중요한 기능을 한다.

우리 몸에서는 매일 암세포가 생겨나고, 각종 세 균과 바이러스도 끊임 없이 우리 몸에 들어오기 때문에 NK세포는 항상 이런 싸움을 벌이고 있는 셈이다. NK세포가 제 역할을 하는지 확인하는 검사 항목 중에 ‘NK세포 활성도’라는 게 있는데, 이 항목 수치가 낮으면 NK세포가 암과 싸울 능력이 떨어지는 것으로 해석한다.
조성훈 차의과대학 교수는 “NK세포 활성도는 과로, 스트레스, 음주, 수면의 질 등의 영향을 받기도 하지만 병이 있는 사람을 찾아내는 민감도는 87%로 높은 편”이라며 “3개월마다 1~2회 검사를 해서 수치가 100 피코그램/mL 이하가 계속 되면 면역에 문제가 있는 것”이라고 말했다. 암환자의 경우 NK세포 활성도 검사 수치가 100 이하인 경우가 많다. NK세포 활성도 수치에서 1피코그램은 1000억분의1 그램이다.
NK세포의 수를 늘려 암과 싸우게 만드는 NK세포 면역치료는 부작용이 생기는 항암제를 쓰지 않아 환자의 삶의 질이 떨어지지 않는다는 점 때문에 환자들이 관심을 갖는 치료법이다. 환자의 혈액에서 추출한 NK세포를 체외에서 배양한 뒤 다시 환자에게 투여하는 방식으로 진행되는 데 보통 사전 검사부터 혈액 재투여까지 3~4주 정도 걸린다.

NK세포를 2주간 배양하면 수가 600~1800배로 증가하는데, 이렇게 늘어난 NK세포를 포함한 혈액을 40분~1시간에 걸쳐 정맥 주사하면 치료 절차는 끝난다. 환자의 혈액으로 진행되는 사전 검사에서는 총 30여개 항목의 수치를 확인하게 되는데, 여러 암 표지자는 물론이고 NK세포 면역치료의 효과를 예측해볼 수 있는 검사도 포함돼 있다.
NK세포 면역치료의 효과를 기대하기 어렵다는 의견도 많다. NK세포를 체외에서 배양해 수만 늘렸기 때문에 면역 효과의 지속 기간이 제한될 수 밖에 없고, NK세포의 작용을 무력화시키는 암세포의 교란 작전(면역관문)의 영향을 받는다는 것이다. 이 때문에 최근에는 암환자가 암세포의 교란작전을 무력화시킬 수 있는 몸 상태인지를 확인하는 검사를 미리 해서, 해당되는 경우((항 PD-1 발현율 50% 이상)에만 NK세포 면역치료를 하고 있다.

NK세포 면역치료를 받으려면 일본 등 외국으로 가야 한다. 이 치료법은 세포치료(살아있는 세포를 환자에게 직접 주입하는 치료) 중 하나인데, ‘모든 세포치료제는 약사법에 따라 임상을 통한 품목 허가를 받아야 한다’는 규정으로 인해 국내에서는 치료가 금지돼 있다. 이 때문에 국내에서는 사전 검사 등 허가된 절차를 밟고, 일본에서 이 치료를 받는 환자들도 있다.

